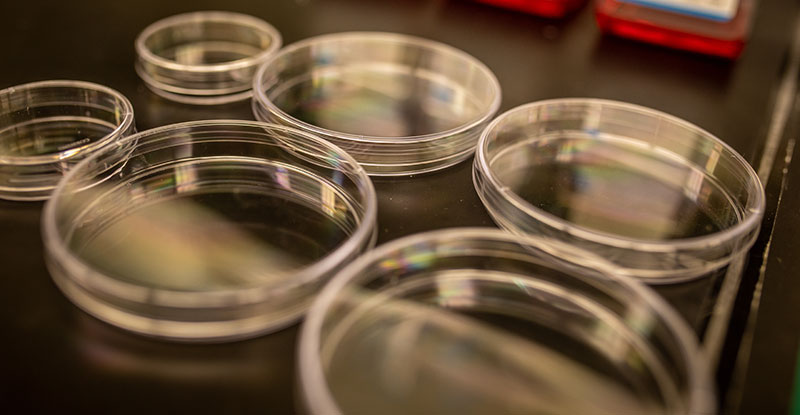
Petri dishes

Master of Science
Program Details
The Chemical Engineering Master’s program at Michigan State University (MSU) provides students from both chemical engineering and other science and engineering undergraduate backgrounds with a curriculum and a variety of technical trainings that prepares them to succeed in industry. Specifically, students can choose courses or training opportunities offered by other departments in the College of Engineering and in other Colleges at Michigan State University tailored to the students’ career goals and background. Depending on the students’ interest in research, MSU offers research implemented master's degree (Plan A, thesis option) in addition to the traditional course-based master's degree (Plan B, non-thesis option).
For students who do not have a background in chemical engineering, collateral classes of “Foundations in Chemical Engineering”, a program of accelerated online courses, are provided as prerequisites to the graduate study in Chemical Engineering. These courses can be taken before formally entering the master's program.
Application Process
Michigan State University uses a decentralized admissions process for graduate studies. Visit the College of Engineering Graduate Admissions page for details on the overall process.
The Department of Chemical Engineering and Materials Science graduate admissions process is as follows:
Fill out a complete MSU Graduate School Application. Use the online forms, or contact gradschool@grd.msu.edu to check on the availability of a paper application. Note the following degree codes:
- Chemical Engineering M.S. = 2303
- Chemical Engineering Ph.D. = 2304
- Materials Science and Engineering M.S. = 8001
- Materials Science and Engineering Ph.D. = 8002
Please Note: Applications completed prior to January 5 will receive full consideration. Your application cannot be marked complete until your application fee has been paid.
Completing the MSU application online will give you access to the student portal. You will be able to:
- Upload Resume/CV
- Upload personal and academic statements
- Manage Letter of Recommendations (see guidelines below).
- Upload any other pertinent information for your application.
- For MS students only: Affidavit of Support and bank statements.
- Send Messages to the Graduate Secretary and Graduate Director.
The following items must be submitted in an official capacity:
- Copy of your official transcripts (undergraduate and graduate). Note: for paper copies, please have official correspondence sent to department. Please contact the Graduate Secretary if you wish to have electronic copies sent, as they must meet certain criteria.
- GRE Scores are currently not required.
- Official TOEFL or IELTS scores (international applicants only). (See Guidelines).
Official test scores (GRE and TOEFL) must be submitted to the University via the Educational Testing Service (ETS). Unofficial photocopies of scoresheets are useful for review purposes, but we cannot admit applicants without a complete application, which requires official scores.
Arrange for three recommendations from instructors and/or advisors familiar with your academic record who have agreed to write a letter of recommendation for you. This may be done via the student portal (step 2) or by mail. The student portal allows for the student to add referrers, send reminder emails and waive their right to view letters.
For mail submissions, please use our CHEMS Recommendation Form (Word document, .doc) (rather than the form provided by the graduate school.) Fill out and sign the top portion of each form. Ask the recommender to complete the form, attach a letter if they wish, and return it to us at the departmental address given on the bottom of the form.
Address for Mailing ALL Printed Application Materials
Graduate Secretary
Department of Chemical Engineering and Materials Science
Michigan State University
428 S. Shaw Ln Rm 2100
Engineering Building
East Lansing, MI 48824-1226
Phone: (517) 355-5135
FAX: (517) 432-1105
grad_rec@egr.msu.edu
Applications will only be reviewed when complete and official. Please utilize the student portal for up-to-date information about your application status.